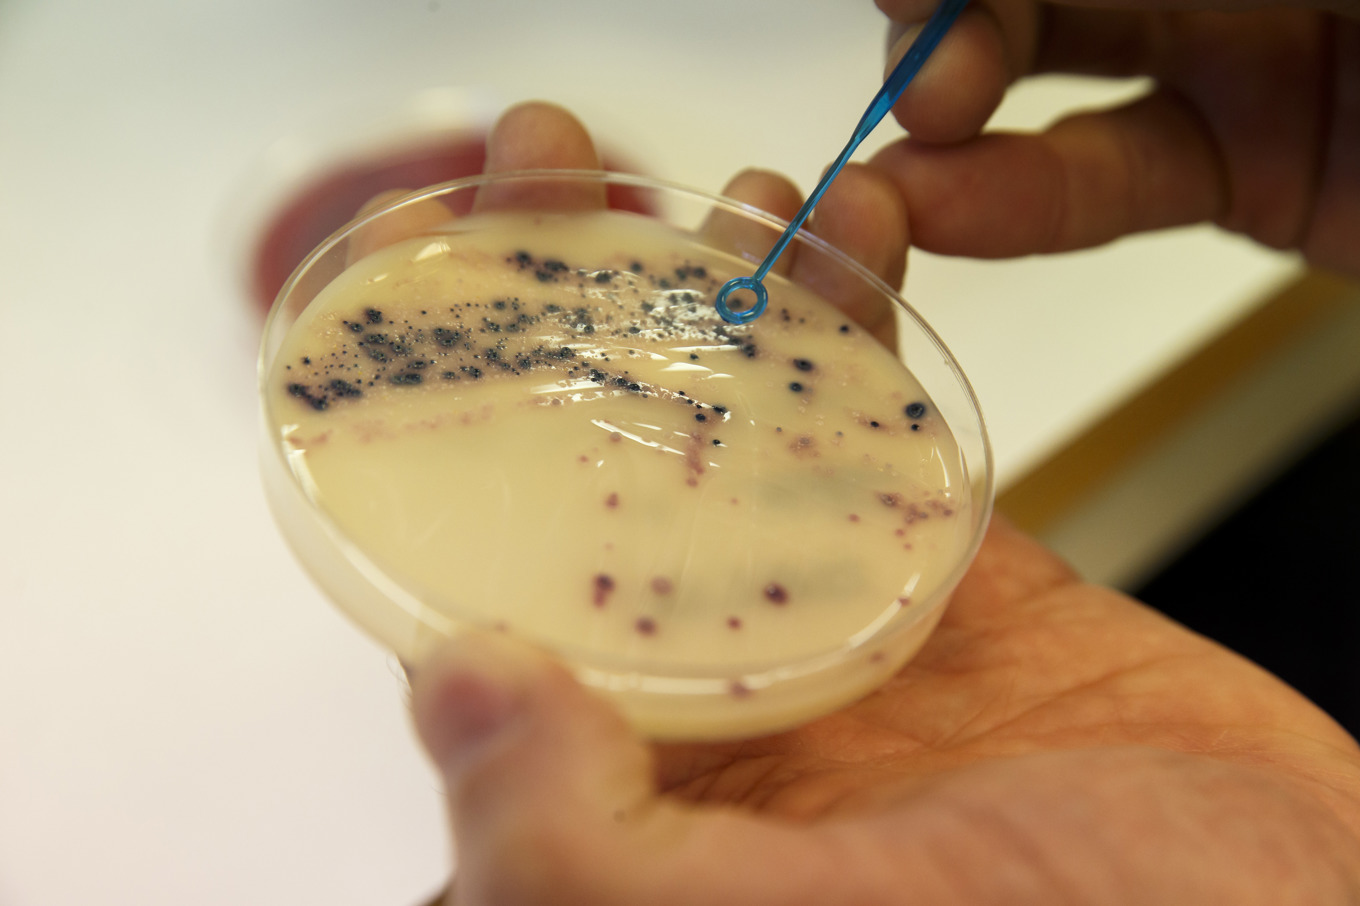
Europeiska smittskyddsmyndigheten har studerat förekomsten av den multiresistenta bakteriestammen. Arkivbild. Foto: Cornelius Poppe/NTB/TT

En multiresistent stam av E. coli-bakterien sprids snabbt i Europa, enligt Folkhälsomyndigheten som beskriver spridningstakten som ”oroande”.
Myndigheten hänvisar till en ny studie från Europeiska smittskyddsmyndigheten som visar hur den resistenta bakteriestammen spridits inom och mellan europeiska länder.
– Studien är ytterligare ett bevis på den allvarsamma ökningen av multiresistenta bakterier som riskerar att minska möjligheten att behandla svåra bakteriella infektioner framöver. Skyndsamma åtgärder krävs för att motverka spridning av antibiotikaresistenta bakterier i Sverige och globalt, säger Vilhelm Müller, utredare på Folkhälsomyndigheten, i ett pressmeddelande.
Bakteriestammen som studerats har fått fäste och spridits även i Sverige, och är resistent mot flera vanliga behandlingsalternativ som exempelvis bredspektrumantibiotika.